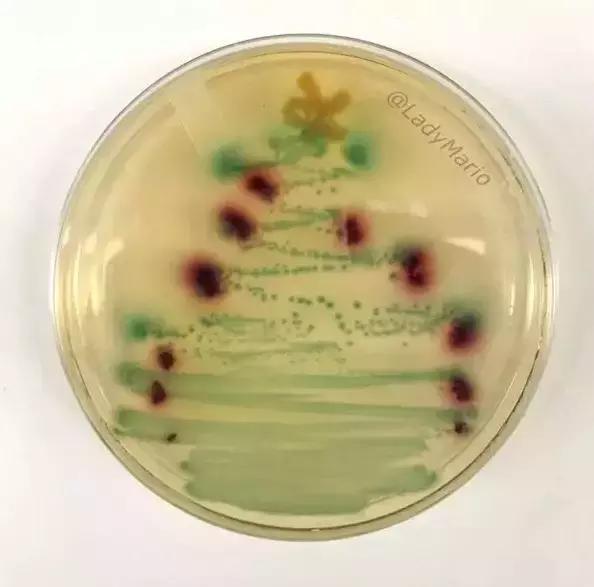
圣诞树也有新花样,YOYO特意送给你看看

叮叮当,叮叮当,铃儿响叮当
欢乐、清脆的Jingle Bells乐曲
彰显着这一天的好心情
街边圣诞树的灯光早已亮起
你感受到这份喜悦了吗
除了各大百货街边的圣诞树
家里的圣诞树也格外美丽
不仅如此哦
YOYO还发现各种不同样子不同形态的圣诞树
想看吗?
赶快跟着YOYO来吧
最有知识的圣诞树
▼
如果今天去图书馆
说不定就会看到这种奇幻场景
在图书馆人员的心灵手巧下
一颗充满知识的圣诞树诞生啦
如果想知识大一点、厚一点
这样的堆砌手法真的不错
看到之后相信明年的自己
一定更加博学!
看一眼黑人问号脸
看两眼到底是什么?
智慧的YOYO告诉你
用细菌做成的超迷你圣诞树!
这棵「树」应该是活的
3D场景圣诞树
▼
穿墙而过,水火相融
想不到没关系
看懂就行
求求你给其它圣诞树留点活路
破房而出你真是史上第一颗
立体壮大
绿色为基垫五彩为装饰
动手能力棒呆
建筑范儿圣诞树
▼
原木墩构成一个11米高的圣诞树
而且还能物尽其用
圣诞过后需要的家庭领走当壁炉的木条
暖心!!!
浸没式的圣诞森林体验
体现对自然和传统的再创造
浸入到深处
在灯光的变幻下
任何奇妙的幻想都有可能
也许你不相信他是圣诞树
走入进去,格状展示在面前
充满着结构的特色
外面看,格状亭美得发光
“天空为界”的归名确实符合他的风格
245个手工吹制的玻璃吊灯组成
轻盈的圣诞树好像会飞起来
无论是单个还是整体
都像圣诞树
无论是清晨还是夜晚
好看到YOYO为他吹爆
圣诞树理应和白雪皑皑的背景相配
没有雪的话就用冰吧
把圣诞树冻在“大冰块”里
营造一个难得一见独一无二的组合
最可爱的圣诞树
▼
黄身体蓝裤子单眼看
这是斯图尔特吧
没想到小黄人还能做成圣诞树
厉害的呢
百货能做成这样真的尽力了
泰迪熊的堆砌远看像圣诞树
近看也还好吧
但是胜在可爱
树上长满了宝可梦
好像要一只皮卡丘啊
乳胶手套也能成为圣诞树
你憋说,还蛮好看!
DIY圣诞树
▼
一串灯泡配墙角
简简单单的装饰搭配成为家的闪亮一角
用家庭成员的照片拼接成为了
一颗有爱暖心的圣诞树
小朋友的五彩世界
用色彩堆砌圆他的梦想
是最有意义的圣诞树了
大妈们真的不能输
▼
水果大妈首先简单出手
迷你圣诞树,能看也能吃
食堂大妈不堪示弱
黄瓜与辣椒天下无敌
超市大妈不服了
迷你算什么
大型蔬菜水果圣诞树
才是大妈界的传奇
看完那么多
你还认为圣诞树都长一个样子吗
一样的圣诞节不一样的圣诞树
你还喜欢哪种圣诞树
留言告诉YOYO吧
最后YOYO祝大家圣诞快乐!!!